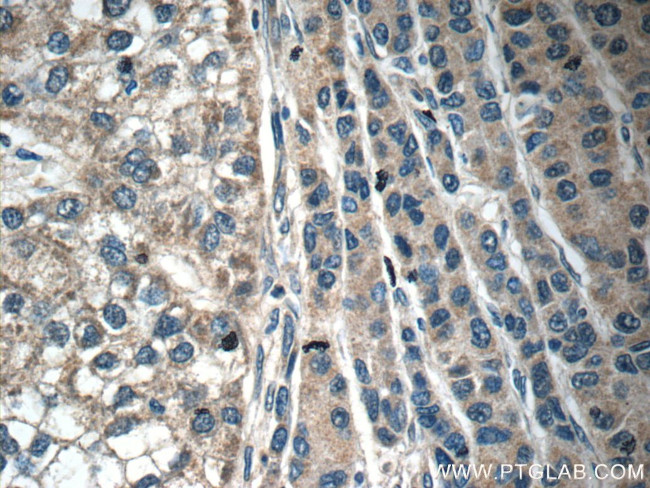
C6 Antibody in Immunohistochemistry (Paraffin) (IHC (P))

Search
Proteintech
C6 Polyclonal Antibody
{{$productOrderCtrl.translations['antibody.pdp.commerceCard.promotion.promotions']}}
{{$productOrderCtrl.translations['antibody.pdp.commerceCard.promotion.viewpromo']}}
{{$productOrderCtrl.translations['antibody.pdp.commerceCard.promotion.promocode']}}: {{promo.promoCode}} {{promo.promoTitle}} {{promo.promoDescription}}. {{$productOrderCtrl.translations['antibody.pdp.commerceCard.promotion.learnmore']}}
产品信息
17239-1-AP
种属反应
宿主/亚型
分类
类型
抗原
偶联物
形式
浓度
规格
纯化类型
保存液
内含物
保存条件
运输条件
产品详细信息
Immunogen sequence: TRECNNPAP QRGGKRCEGE KRQEEDCTFS IMENNGQPCI NDDEEMKEVD LPEIEADSGC PQPVPPENGF IRNEKQLYLV GEDVEISCLT GFETVGYQYF RCLPDGTWRQ GDVECQRTEC IKPVVQEVLT ITPFQRLYRI GESIELTCPK GFVVAGPSRY TCQGNSWTPP ISNSLTCEKD TLTKLKGHCQ LGQKQSGSEC ICMSPEEDCS HHSEDLCVFD TDSNDYFTSP ACKFLAEKCL NNQQLHFLHI GSCQDGRQLE WGLERTRLSS NSTKKESCGY DTCYDWEKCS ASTSKCVCLL PPQCFKGGNQ LYCVKMGSST SEKTLNICEV GTIRCANRKM EILHPGKCLA (586-934 aa encoded by BC035723)
靶标信息
C6 is a component of complement cascade. It is part of the membrane attack complex which can insert into the cell membrane and cause cell to lyse. People with C6 deficiency are prone to bacterial infection. Two transcript variants encoding the same protein have been found for this gene.
仅用于科研。不用于诊断过程。未经明确授权不得转售。
生物信息学
蛋白别名: complement component 6; Complement component C6; complement component C6 precursor peptide; unnamed protein product
基因别名: AW111623; C6
UniProt ID: (Mouse) E9Q6D8, (Rat) Q811M5, (Human) P13671
Entrez Gene ID: (Mouse) 12274, (Rat) 24237, (Human) 729